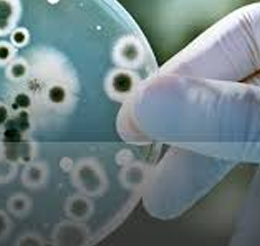

The Department of Microbiology :
Microbiology section of the laboratory provides state-of-art services for diagnosis of infectious diseases - bacterial, mycobacteria, and fungal, parasitic and viral infections. In addition to conventional techniques, the lab is well equipped with automated systems that perform blood culture and mycobacterium culture. Bacterial identification and antimicrobial susceptibility are also performed by automated system reducing the turn around time of reporting.
Serological investigations to determine the antibody/antigens of HIV, HBV, HCV, Dengue, Leptospira, and Cryptococcus etc. are performed besides routine tests like Widal, RA, ASO etc.
The department assists in providing education on infection control practices for healthcare workers. Infection control policies on waste disposal, use of disnfectants and antibiotics have been formulated. The department also provides relevant data in monitoring healthcare associated infections. Constant surveillance is done on Infection control practices in the entire hospital in order to control the infection rate as well as prevent outbreaks.
